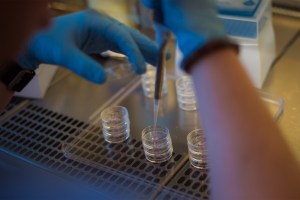
Lab with researcher doing test.

All articles
-
Work & Economy
With federal funds, Harvard helps drive local economy
Harvard University uses its federal research funding to foster economic growth throughout the region.

-
Science & Tech
A great civilization brought low by climate change (and, no, it’s not us)
Human-environmental scientist says there are new clues about how and why the Maya culture collapsed.

-
Arts & Culture
A peek at a critical time for Japan through its art
A new Harvard Art Museums exhibit features more than 120 works from the Feinberg Collection and captures the evolving nature of Japanese painting over more than 200 years.

-
Science & Tech
From YouTube to your school
In a new paper, Harvard researchers show for the first time that research-based online STEM demonstrations not only can teach students more, but can be just as effective as classroom teaching.

-
Science & Tech
What the nose knows
Experts discuss the science of smell and how scent, emotion, and memory are intertwined — and exploited

-
Nation & World
An awakening over data privacy
Shoshana Zuboff of Harvard Business School says democracy is the only antidote to the internet privacy crisis.

-
Campus & Community
African and African American Studies at 50
Influential, groundbreaking African and African American Studies Department at Harvard turns 50.

-
Campus & Community
Shining a light on a genius
Architect Julian Abele is responsible for the design of Harvard’s Widener l Library, where his role, until recently, had gone largely unacknowledged.

-
Science & Tech
From ancient flooding, modern insights
Tamara Pico, a postdoctoral fellow, is using records of flooding in the Bering Strait to make inferences about how the ice sheets that covered North America responded to the warming climate, and how their melting might have contributed to climate changes.

-
Health
Endurance athletes found to have enlarged aortas
A new study has found that like their younger counterparts, a high percentage of endurance athletes aged 50 to 75 years have an enlarged aorta. Now researchers must determine if this is a good thing or a bad thing.

-
Campus & Community
Melinda Gates to receive Radcliffe Medal
Melinda Gates, co-chair of the world’s largest philanthropic organization, will be presented the Radcliffe Medal on May 29.

-
Science & Tech
The good, bad, and scary of the Internet of Things
Radcliffe researcher explores how to create a framework for the Internet of Things that minimizes risk and maximizes safety.

-
Nation & World
Comey defends ‘nightmare I can’t awaken from’
During a Harvard Kennedy School visit, former FBI Director James Comey defends his decisions during the 2016 presidential election.

-
Health
What we know and don’t know about pot
With legal marijuana easier to find, a Harvard professor addresses myths and progress finding answers about pot’s health impacts.

-
Health
Scientists from Harvard, China to unite against coronavirus
With nearly 78,000 cases and more than 2,300 deaths from the novel coronavirus, Harvard University scientists will join forces with colleagues from China to improve diagnostics, develop vaccines to prevent new infections, and antiviral therapies to treat existing ones.

-
Nation & World
Why ‘truth’ beats facts
Harvard Kennedy School discussion takes a look at why we can’t agree on facts any more.

-
Nation & World
Me Too founder discusses where we go from here
Activist and Me Too founder Tarana Burke will receive Harvard Kennedy School’s Center for Public Leadership Gleitsman Award for her work.

-
Nation & World
Harvard librarian puts this war crime on the map
Harvard Fine Arts librarian András Riedlmayer catalogued years of cultural heritage destruction by Serbian nationalists in the Balkans. He then testified to their war crimes before the United Nations.

-
Health
Drop in cancer deaths lifts U.S. life expectancy
A decline in cancer mortality was a prominent feature of recent good news about U.S. life expectancy. The Gazette spoke with the director of the Chan School’s Zhu Family Center for Global Cancer Prevention to understand why.

-
Nation & World
Health officials expect coronavirus to spread worldwide
Latest updates on the new coronavirus from a Facebook Live event sponsored by the Forum at Harvard T.H. Chan School of Public Health and PRI’s The World.

-
Science & Tech
Food that’s better for all of us and the planet
According to a summit on food production, diet, and sustainability, humanity needs to refocus on a diet that encompasses sustainability and social justice.

-
Science & Tech
Beyond Pavlov
Artificial intelligence researchers and neurobiologists share data on how options are sorted in decision-making.

-
Nation & World
Feel that clean air and voting are human rights? It’s partly on you
Harvard Kennedy School professor Kathryn Sikkink discusses a new ethics of responsibilities to deal with climate change, voting, digital privacy, and other pressing issues.

-
Health
In soda tax fight, echoes of tobacco battles
Taxes on sugary drinks are potentially effective tools to fight the obesity epidemic and advocates are drawing lessons from the long battle against tobacco as they plot what they know will be a tough road ahead.

-
Arts & Culture
Unraveling a fine arts mystery
Harvard Art Museums’ restoration and research on a portrait of King Philip has both shed light and raised questions about the copy versus an original.

-
Campus & Community
Getting his teeth into the community
Harvard School of Dental Medicine student Ryan Lisann’s three-month externship at Charles River Community Health Center in Brighton left him determined to enter pediatric dentistry and education.